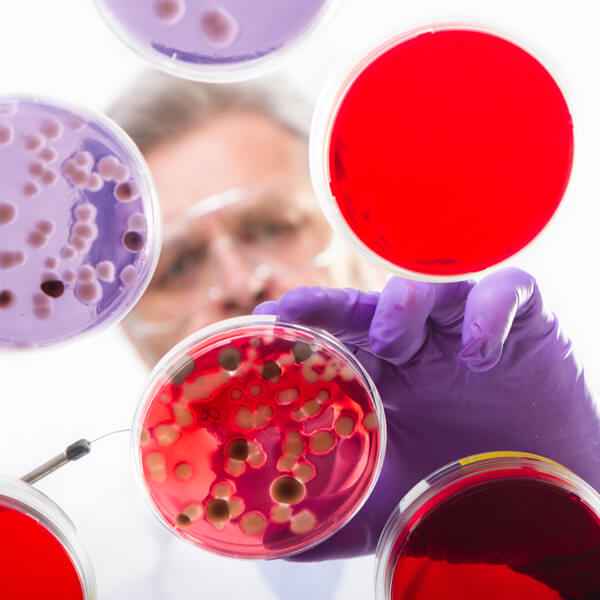
Imagen: Diplomado universitario internacional de novedades y puesta al día en enfermedades infecciosas en pediatría

100 disponibles

Diplomado Internacional: 450 Horas, 18 Créditos ECTS
Diplomado universitario internacional de actualización en geriatría y gerontología II
Diplomado Internacional: 475 Horas, 19 Créditos ECTS
Diplomado universitario internacional de novedades y puesta al día en enfermedades infecciosas en pediatría

Diplomado Internacional: 250 Horas, 10 Créditos ECTS
Diplomado universitario internacional de formación e investigación en urgencias y emergencias sanitarias

Diplomado Internacional: 300 Horas, 12 Créditos ECTS


